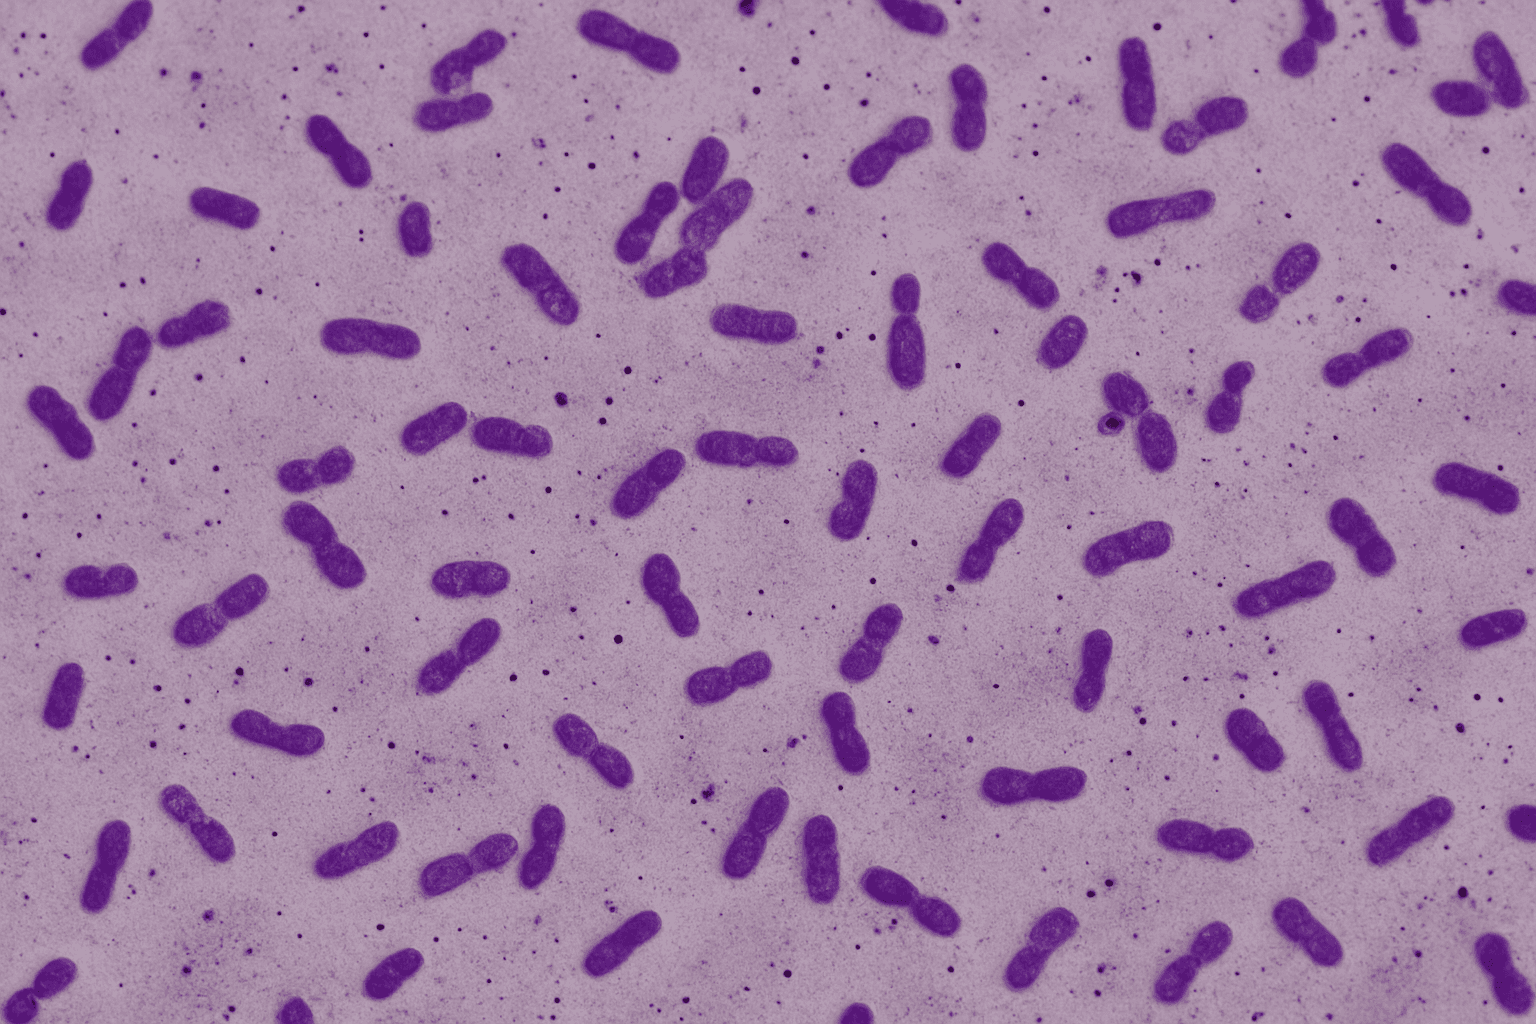

Biome Secret Ingredients
70+
Powerful Ingredients
70+
Powerful Ingredients
30+
Vitamins & Minerals
30+
Vitamins & Minerals
100%
Natural & Whole-Sourced
No Soy
gluten-free
No Trans fat
Lactose-free
Nut-free
no hormones
Non-GMO
Vegan
No Soy
gluten-free
No Trans fat
Lactose-free
Nut-free
no hormones
Non-GMO
Vegan
No Soy
gluten-free
No Trans fat
Lactose-free
Nut-free
no hormones
Non-GMO
Vegan
All-In-One Bundle
Weight-Loss Meal
Metabolism Booster+
Bloating Relief+
Ingredients of
All-In-One Bundle
All-In-One Bundle
Weight-Loss Meal
Metabolism Booster+
Bloating Relief+
Choose Your Natural Win
Sign up for the Biome Secret Newsletter and Secure Your Offer
DISCLAIMER
The statements on this page have not been evaluated by the Food and Drug Administration (FDA). Our products are not intended to diagnose, treat, cure, or prevent any disease. Consult with a healthcare professional before starting any dietary or wellness program. The mention of any external brands on our site does not imply their endorsement of our products. We independently select and share these brands to complement our offerings without any implied partnerships or endorsements.
© Biome Secret 2025
Sign up for the Biome Secret Newsletter and Secure Your Offer
DISCLAIMER
The statements on this page have not been evaluated by the Food and Drug Administration (FDA). Our products are not intended to diagnose, treat, cure, or prevent any disease. Consult with a healthcare professional before starting any dietary or wellness program. The mention of any external brands on our site does not imply their endorsement of our products. We independently select and share these brands to complement our offerings without any implied partnerships or endorsements.
© Biome Secret 2025
Sign up for the Biome Secret Newsletter and Secure Your Offer
DISCLAIMER
The statements on this page have not been evaluated by the Food and Drug Administration (FDA). Our products are not intended to diagnose, treat, cure, or prevent any disease. Consult with a healthcare professional before starting any dietary or wellness program. The mention of any external brands on our site does not imply their endorsement of our products. We independently select and share these brands to complement our offerings without any implied partnerships or endorsements.
© Biome Secret 2025
Sign up for the Biome Secret Newsletter and Secure Your Offer
DISCLAIMER
The statements on this page have not been evaluated by the Food and Drug Administration (FDA). Our products are not intended to diagnose, treat, cure, or prevent any disease. Consult with a healthcare professional before starting any dietary or wellness program. The mention of any external brands on our site does not imply their endorsement of our products. We independently select and share these brands to complement our offerings without any implied partnerships or endorsements.
© Biome Secret 2025